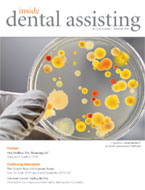

Don't miss an issue! Renew/subscribe for FREE today.
×
Table of Contents
Feature Article
Oral Biofilms: The "Balancing Act"
Margaret I. Scarlett, DMD
Columns
The Main Ingredient
Robert Evans Wilson, Jr.
Health & Safety
Cleaning Instruments: A Critical Step to Instrument Reprocessing
Eve J. Cuny, RDA, MS



